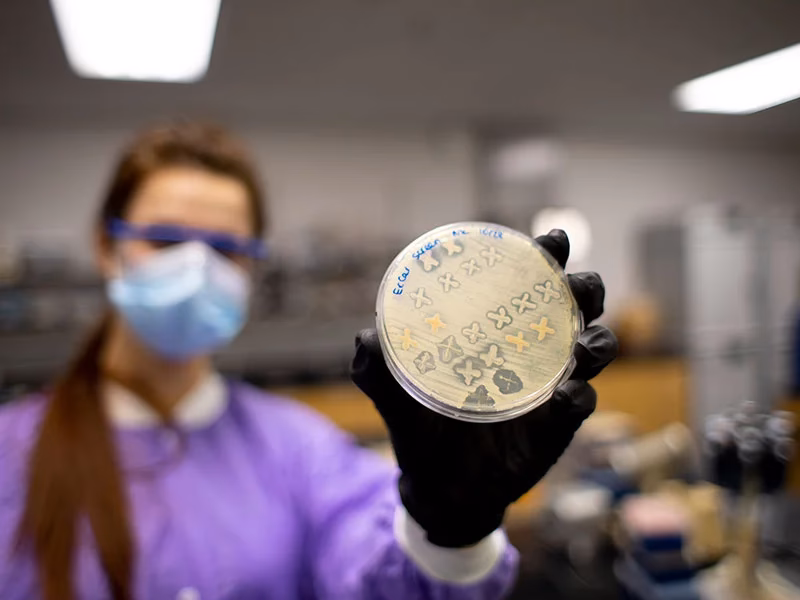

Adentrarse en el perfil académico de una institución educativa como Luther College implica analizar diversas métricas que delinean el entorno de aprendizaje y las preferencias de los estudiantes. Al examinar los datos disponibles, podemos construir una imagen clara de cómo es la experiencia educativa dentro de sus muros, enfocándonos en aspectos cruciales como la interacción directa con el profesorado, el tamaño de las aulas y las áreas de estudio que captan mayor interés entre la población estudiantil.

Una de las características más distintivas de Luther College es su compromiso con un entorno de aprendizaje íntimo y personalizado. Esto se refleja directamente en su ratio estudiante-profesor de 10:1. Este número sugiere que, en promedio, hay solo diez estudiantes por cada miembro del cuerpo docente. Un ratio bajo como este es a menudo indicativo de una mayor oportunidad para la interacción individualizada, discusiones más profundas en clase y un acceso más fácil a la orientación por parte de los profesores. Este tipo de ambiente puede ser especialmente beneficioso para el desarrollo académico y la construcción de relaciones sólidas entre estudiantes y educadores, lo que a su vez puede influir positivamente en la experiencia general del estudiante.
El Tamaño de las Clases: Un Factor Clave
Complementando el favorable ratio estudiante-profesor, las estadísticas sobre el tamaño de las clases en Luther College refuerzan la idea de un entorno de aprendizaje centrado en el estudiante. Se reporta que un impresionante 71.6% de sus clases cuentan con menos de 20 estudiantes. Este porcentaje subraya que la vasta mayoría de las experiencias en el aula en Luther College ocurren en formatos de grupo reducido. Las clases reducidas facilitan metodologías de enseñanza más interactivas, permiten que los profesores presten atención individualizada a las necesidades de cada estudiante y fomentan una participación más activa por parte de todos los presentes. En contraste con las grandes aulas de conferencias típicas de instituciones con mayor número de alumnos, un modelo basado en clases pequeñas puede promover un aprendizaje más profundo y colaborativo.
Las Áreas de Estudio de Mayor Interés
El análisis de las carreras más populares en Luther College nos ofrece una perspectiva sobre las áreas de conocimiento que atraen a la mayor parte de su alumnado. Este listado no solo refleja las demandas del mercado laboral o los intereses intrínsecos de los estudiantes, sino también, potencialmente, la fortaleza y calidad percibida de los programas ofrecidos por la institución en esas disciplinas. A continuación, se presenta una lista de las carreras más demandadas:
| Área de Estudio | Categoría General |
|---|---|
| Biología/Ciencias Biológicas | General |
| Administración y Gestión de Empresas | General |
| Enfermería Registrada | Enfermera Registrada |
| Psicología de Investigación y Experimental | Otra |
| Lengua y Literatura Inglesa | General |
| Ciencia/Estudios de la Información | |
| Música | General |
| Ciencias Políticas y Gobierno | General |
| Ciencia de la Computación | |
| Diseño y Comunicaciones Visuales | General |
Como se observa en la tabla, las preferencias se distribuyen en una variedad de campos, abarcando desde las ciencias puras y aplicadas (Biología, Enfermería, Ciencia de la Computación) hasta las humanidades y artes (Lengua Inglesa, Música, Diseño) y las ciencias sociales y empresariales (Administración de Empresas, Psicología, Ciencias Políticas). Esta diversidad sugiere que Luther College atrae a estudiantes con una amplia gama de intereses académicos y vocacionales, y que ofrece programas sólidos en múltiples áreas.
Satisfacción Estudiantil y Retención
La tasa de retención de estudiantes de primer año es un indicador crucial de la satisfacción de los alumnos con su experiencia inicial en la universidad y de su decisión de continuar sus estudios en la misma institución. Para Luther College, la tasa promedio de retención de estudiantes de primer año se sitúa en un 80%. Esta cifra es generalmente considerada como un buen indicativo de que la mayoría de los estudiantes que ingresan a la universidad encuentran que la calidad académica, el ambiente social y el apoyo institucional cumplen con sus expectativas y necesidades, motivándolos a regresar para su segundo año. Una tasa de retención saludable sugiere que los estudiantes se sienten apoyados, comprometidos y satisfechos con su elección educativa.
En resumen, el perfil académico de Luther College, basado en los datos proporcionados, pinta el cuadro de una institución que valora la interacción cercana entre estudiantes y profesores a través de ratios favorables y clases pequeñas. Ofrece una selección diversa y popular de programas de estudio que atraen a estudiantes con variados intereses, y demuestra una capacidad notable para retener a sus estudiantes después de su primer año, lo que sugiere un alto nivel de satisfacción general con la experiencia universitaria.
Preguntas Frecuentes
¿Cuál es el ratio estudiante-profesor en Luther College?
El ratio estudiante-profesor en Luther College es de 10:1.
¿Qué porcentaje de clases tienen pocos estudiantes?
El 71.6% de las clases en Luther College tienen menos de 20 estudiantes.
¿Cuáles son las carreras más populares en Luther College?
Las carreras más populares incluyen Biología, Administración de Empresas, Enfermería, Psicología (Investigación y Experimental), Lengua y Literatura Inglesa, Ciencia/Estudios de la Información, Música, Ciencias Políticas y Gobierno, Ciencia de la Computación, y Diseño y Comunicaciones Visuales.
¿Qué tan satisfechos están los estudiantes de primer año en Luther College?
La tasa promedio de retención de estudiantes de primer año es del 80%, lo que se considera un buen indicador de satisfacción estudiantil.
¿Un ratio estudiante-profesor bajo es importante?
Sí, un ratio bajo como 10:1 generalmente indica más oportunidades para la interacción individualizada con los profesores y una atención más personalizada en el proceso de aprendizaje.
¿El tamaño de las clases afecta el aprendizaje?
Las clases con menos de 20 estudiantes, como el 71.6% en Luther College, suelen facilitar la participación activa, el debate y una mejor interacción entre compañeros y el profesor, potencialmente mejorando la comprensión y el compromiso con la materia.
¿La tasa de retención solo mide satisfacción?
Aunque la tasa de retención es un indicador clave de la satisfacción estudiantil, también puede reflejar otros factores como la efectividad del apoyo académico y estudiantil, la calidad de la vida en el campus y la pertinencia de los programas de estudio ofrecidos por la institución.
Si quieres conocer otros artículos parecidos a Perfil Académico de Luther College puedes visitar la categoría Carrera.